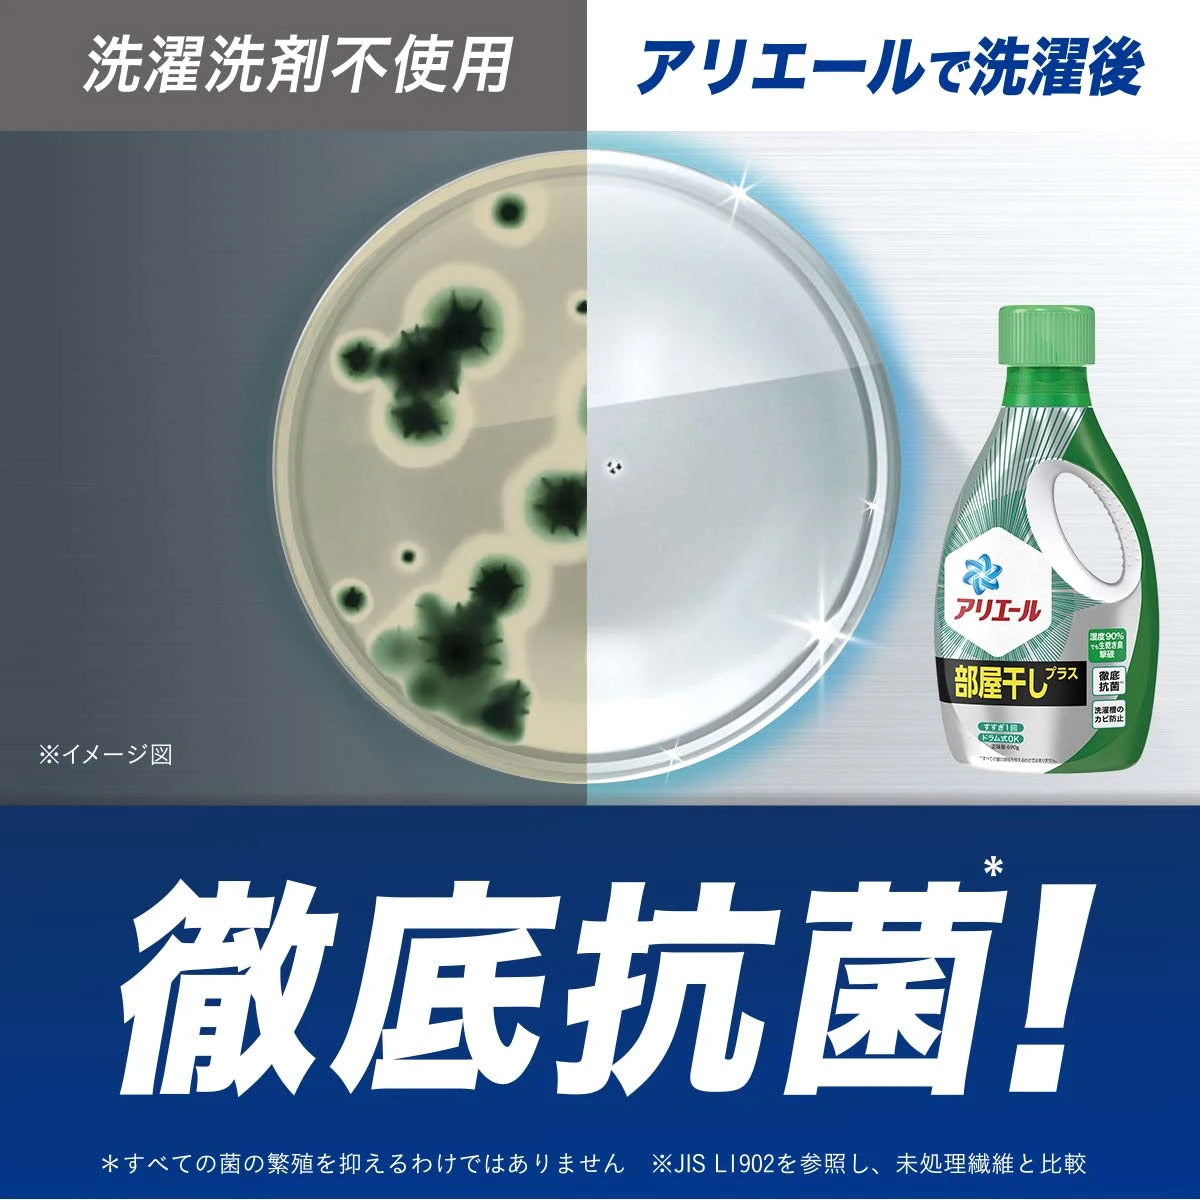

P&G
アリエール ジェル 部屋干し 詰め替え ウルトラジャンボ 1680g
アリエール ジェル 部屋干し 詰め替え ウルトラジャンボ 1680g
通常価格
758 円
通常価格
セール価格
758 円
単価
あたり
(税込み)
配送料はチェックアウト時に計算されます。
受取状況を読み込めませんでした
※カートに追加すると配達日時指定が可能になります。
消臭成分2倍で、煮沸レベルの消臭力。タオルの生乾き臭も徹底消臭&徹底抗菌で、気になる臭いを防げます。
洗濯槽クリーナーなしでもカビ防止ができるから、忙しいママにもオススメ!
快適に部屋干しができます◎
詰め替え ウルトラジャンボ 1680g